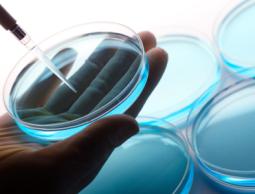

قالت صحيفة معاريف العبرية، إن علامات التغيير في النظام اليومي لرئيس السلطة محمود عباس ازدادت في الأشهر الأخيرة، مضيفة أن التقدّم في السنّ بدأ يؤثر عليه، وأن طبيبه الخاص يلازمه طيلة الوقت.
وبحسب معاريف، في عددها الصادر اليوم السبت، فإن تقارير من الحكومة أفادت بأن أبو مازن أصبح يدير الأمور بعصبية وبقسوة في المناقشات الداخلية، والمعلومات حول عاداته تثير القلق من أن التقدم في السن قد بدأ بالفعل يؤثر عليه.
وذكرت أن أبو مازن دخل عامه الـ 82، وهو مدخن بشراهة، وحالته تدهورت مؤخرا، قائلة إن "هذا ما قد يؤثر على قراراته وصلاحياته في إدارة السلطة في الأوقات القادمة، وما قد يؤثر على مستقبل التنسيق الأمني من حالة استمراره أو تغيير في طريقته".
وكان صحيفة هآرتس العبرية نشرت نهاية شهر يوليو الماضي أن جهاز الشاباك الإسرائيلي يتابع بقلق الحالة الصحية للرئيس عباس، على خلفية تردد أنباء عن دخوله المستشفى لإجراء فحوصات طبية، قبل أن تورد وكالة الأنباء الفلسطينية (وفا) أن أبو مازن أجرى "فحوصات روتينية".
وقالت هآرتس إن أبو مازن يعتبر مدخنا ثقيلا، رغم أنه غيّر من عادته هذه مؤخرا، وانتقل لتدخين السجائر الالكترونية.
وذكرت أنه في وقت سابق من هذا العقد تم علاج أبو مازن من سرطان البروستاتا، لكن تم تشخيص مشاكل في القلب لديه لاحقاً.
وأبو مازن، من مواليد صفد عام 1935، ويبلغ من العمر 82 عاما.
وشهدت الفترة الأخيرة مواقف وتصريحات دللت على سلوك عصبي للرئيس عباس، منها تهجمه على ممثل الجبهة الشعبية عمر شحادة في اجتماع للجنة التنفيذية لمنظمة التحرير، ونعته بـ "السافل".
وسبق أن تطاول على النائب في المجلس التشريعي خالدة جرار التي طالبت بوقف التنسيق الأمني.
وتعتقد مصادر إسرائيلية وفلسطينية أن صحة الرئيس عباس تدهورت في الأشهر الأخيرة، وأن أي تفاقم آخر يمكن أن يعجل من تغيير رئيس السلطة الفلسطينية.